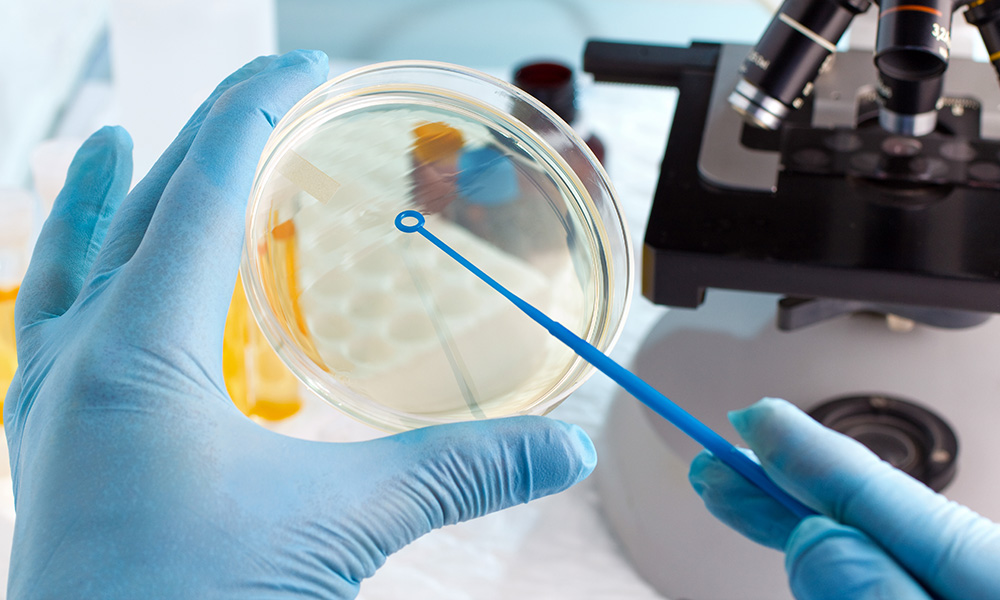

This course is designed for first-year Master's students specializing in applied microbiology. The objective of this course is to enable students to acquire policy of microbiological control of a product and mastery the various standardized techniques or methods used in the microbiological control of foodstuffs and the various analysis schemes.
The course is divided into a set of learning units that allow you to acquire skills in various sampling techniques. The course also allows students to acquire knowledge of direct and indirect counting methods and how to analyze a pharmaceutical product.
- Enseignant: Khadidja Fellah
- Enseignant: chouaib selkh
La taxonomie des microorganismes est l'étude des principes, des méthodes et des pratiques utilisées pour classer et identifier les microorganismes. Cette discipline repose sur une hiérarchie systématique d’organisation des êtres vivants : domaine, phylum, classe, ordre, famille, genre, espèce.La biodiversité des microorganismes désigne la variété et la variabilité des microorganismes présents dans l’environnement, que ce soit dans des habitats naturels ou artificiels. Elle inclut des bactéries, des archées, des virus, et des champignons .
- Enseignant: bendjima khadidja

Objectif de l’enseignement
L'objectif de ce module est d'aider les étudiants à comprendre le fonctionnement des cellules microbiennes. Il vise également à approfondir la connaissance de la diversité fonctionnelle des communautés microbiennes dans les écosystèmes, tout en optimisant les processus biologiques.- Enseignant: Ahmed BOULAL